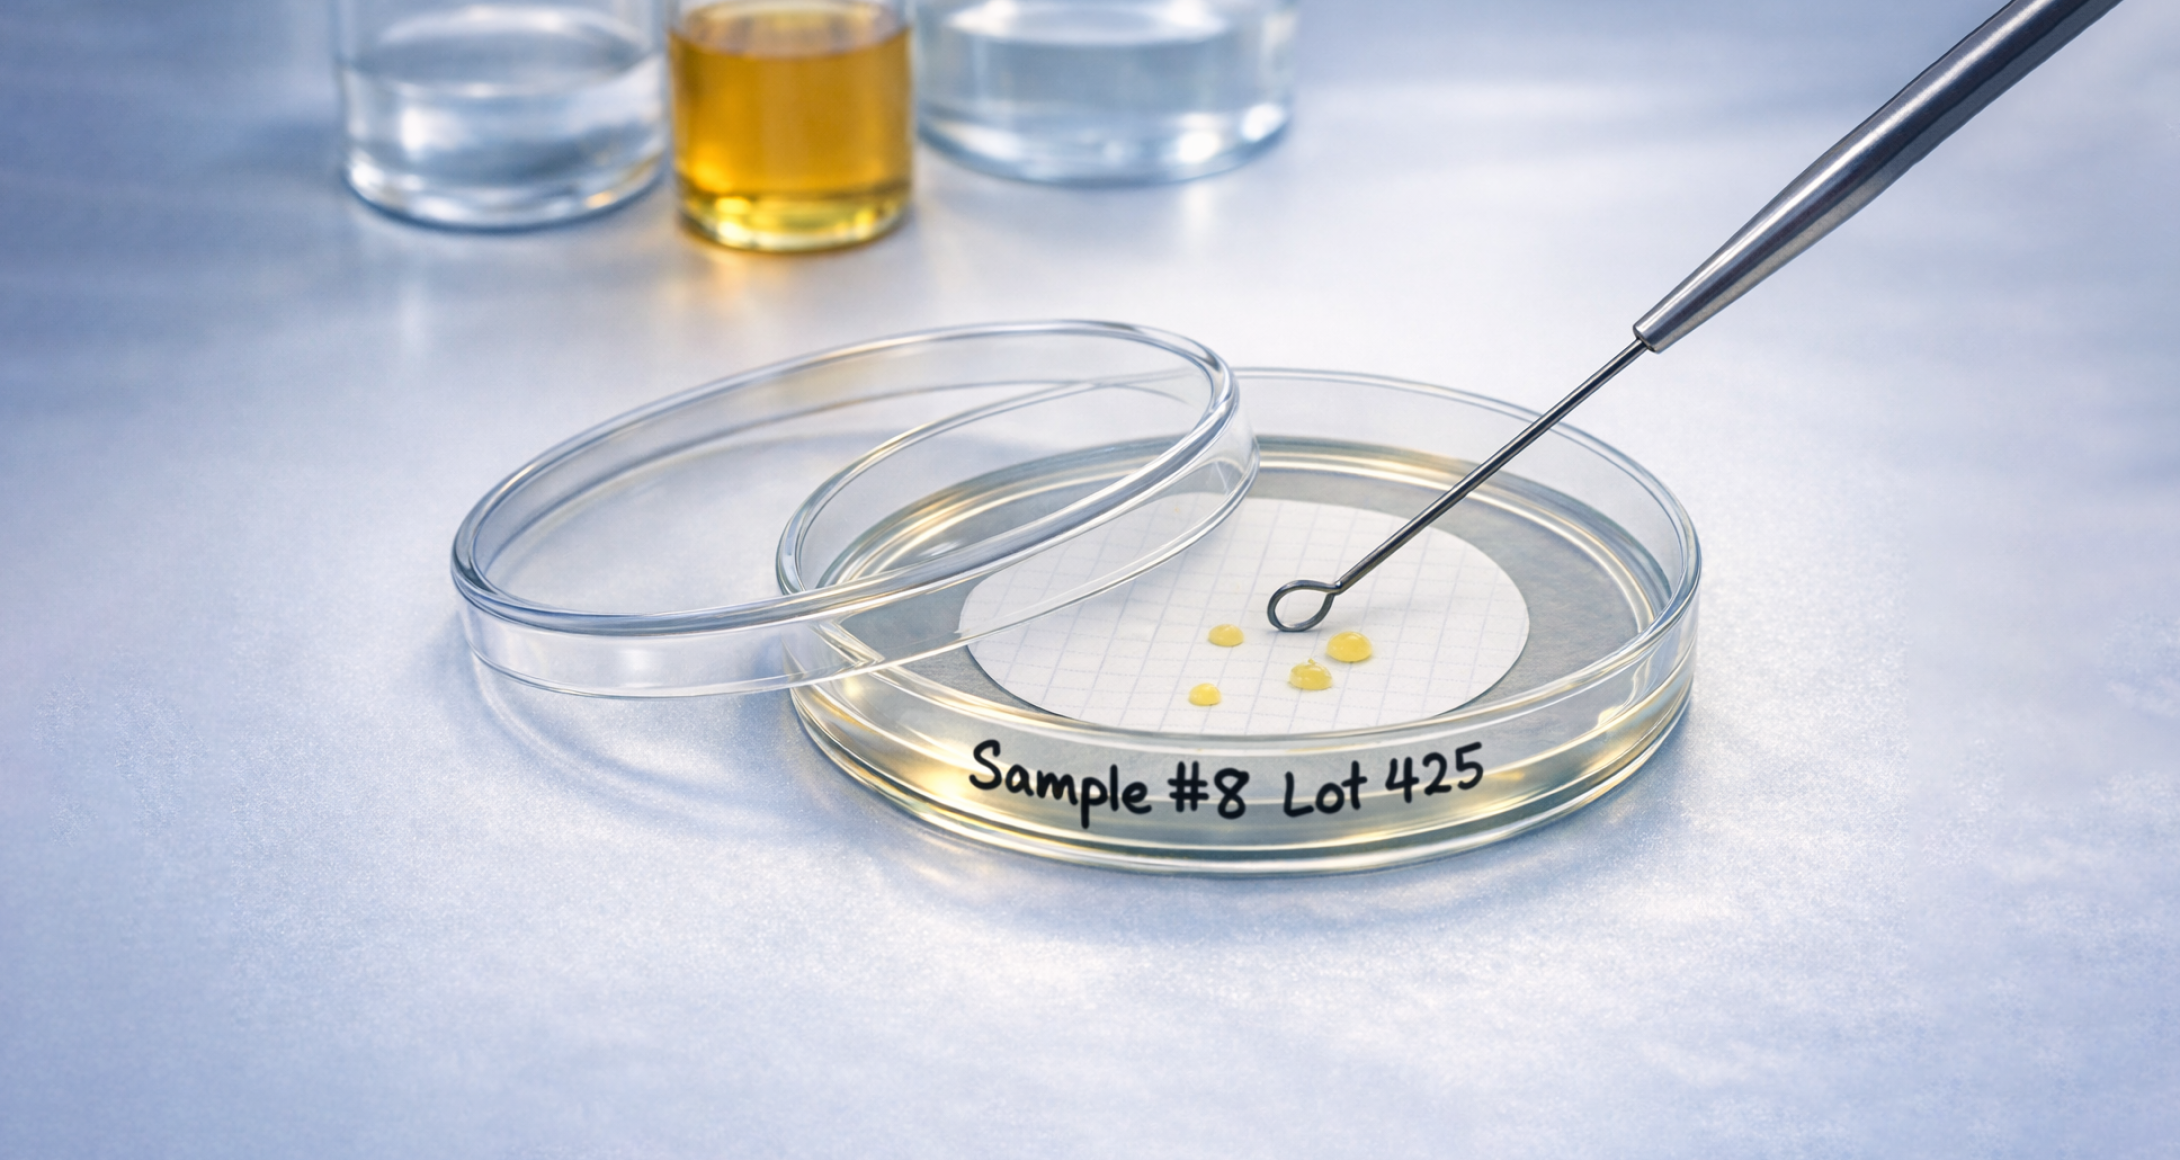
Bioburden Bestimmung

Neu bei Früh: Sterilisationsservices – modular, koordiniert, dokumentiert
Sterilisation und mikrobiologisches Monitoring werden anspruchsvoller – und qualifizierte Ressourcen sind knapp. Mit den modularen Sterilisations- & Monitoring-Services von Früh sichern Sie Compliance, gewinnen Planungssicherheit und holen sich gezielt die Expertise, die Ihnen gerade fehlt: von Bioburden/Endotoxin über Validierung & auditfähige Dokumentation bis Execution Support (Gamma/X-Ray, Dampf, EtO).
Früh Verpackungstechnik setzt genau hier an und ergänzt seine bestehenden Dienstleistungen um koordinierte Sterilisationsservices sowie mikrobiologisches Monitoring und Validierungs-Support.
Sie können ab sofort Sterilisations-Services ab sofort einzeln oder als abgestimmtes kundenspezifisches Paket anfragen – von Bioburden über Dose Audits bis in hin zur Dose Mapping Validierung (Gamma & X-Ray) sowie EtO- & Dampf-Validierung. Wir koordinieren die Planung, Durchführung und Dokumentation in enger Abstimmung mit Ihrem Team und unseren qualifizierten Partnern.
Detaillierte Infos finden Sie im neuen Serviceflyer.
Services beauftragen
Für neue und wiederkehrende Serviceaufträge nutzen Sie bitte ab sofort unser Bestellformular.
Das PDF-Formular ersetzt das bisherige Worddokument, welches versandt wurde. Für fachliche Detailfragen und die Abstimmung des passenden Vorgehens sind unsere Steri-Expert:innen Alexander Müller und Nicole Buchberger Ihre direkten Ansprechpartner.
Gern klären wir gemeinsam, welche Module für Ihr Produkt und Ihren Zeitplan am sinnvollsten sind.
Ihr Nutzen auf einen Blick
- Ein zentraler Kontakt statt vieler Schnittstellen
- Koordination mit qualifizierten Partnern und klaren Abläufen
- Auditfähige Dokumentation (Protokolle, Reports und Traceability)
- Kategorie:
- FRÜH-Know-how
- Jahr:
- 2026



.png)


.png)